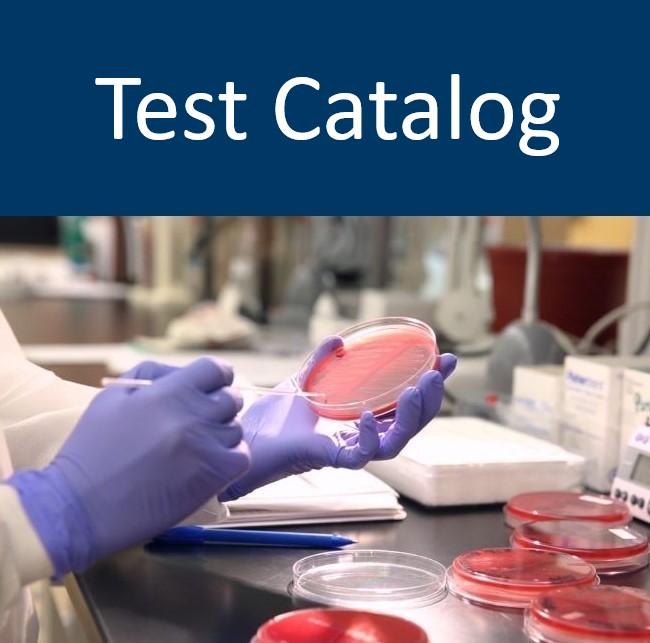

Infectious Disease Laboratory
A section of Minnesota’s Public Health Laboratory
The Infectious Disease Laboratory (IDL) provides surveillance, reference, and diagnostic testing services that are generally not available elsewhere in the state. Laboratories serving Minnesota are required by state statute to submit specific microbial isolates.
In addition, the IDL is prepared to respond to emergencies and outbreaks that threaten the public's health, using some of the most cutting-edge methodologies and equipment available. We also encompass the Minnesota Laboratory System (MLS), and our Emergency Preparedness and Response unit partners with the Environmental Laboratory to constitute Laboratory Emergency Preparedness.
See also:
- About our Lab and its Laboratory Units
- Antibiotic Resistance (AR) Laboratory Network Forms
- CLIA Certificate
- COVID-19 Sample Submission Guidelines for next-generation sequencing
- Disease Spotlight: COVID-19, Measles, Influenza, CRE, Zika, Ebola
- Fee Schedule
- Forms
- Infectious Disease Research Projects within the Pathogen Genomics Centers of Excellence (PGCoE) program, within the Centers for Disease Control and Prevention (CDC)
- Packing and Transport
- Specimen Retention Schedule
- Test Catalog
Please Contact the Infectious Disease Laboratory with any questions.
Last Updated: 08/01/2024